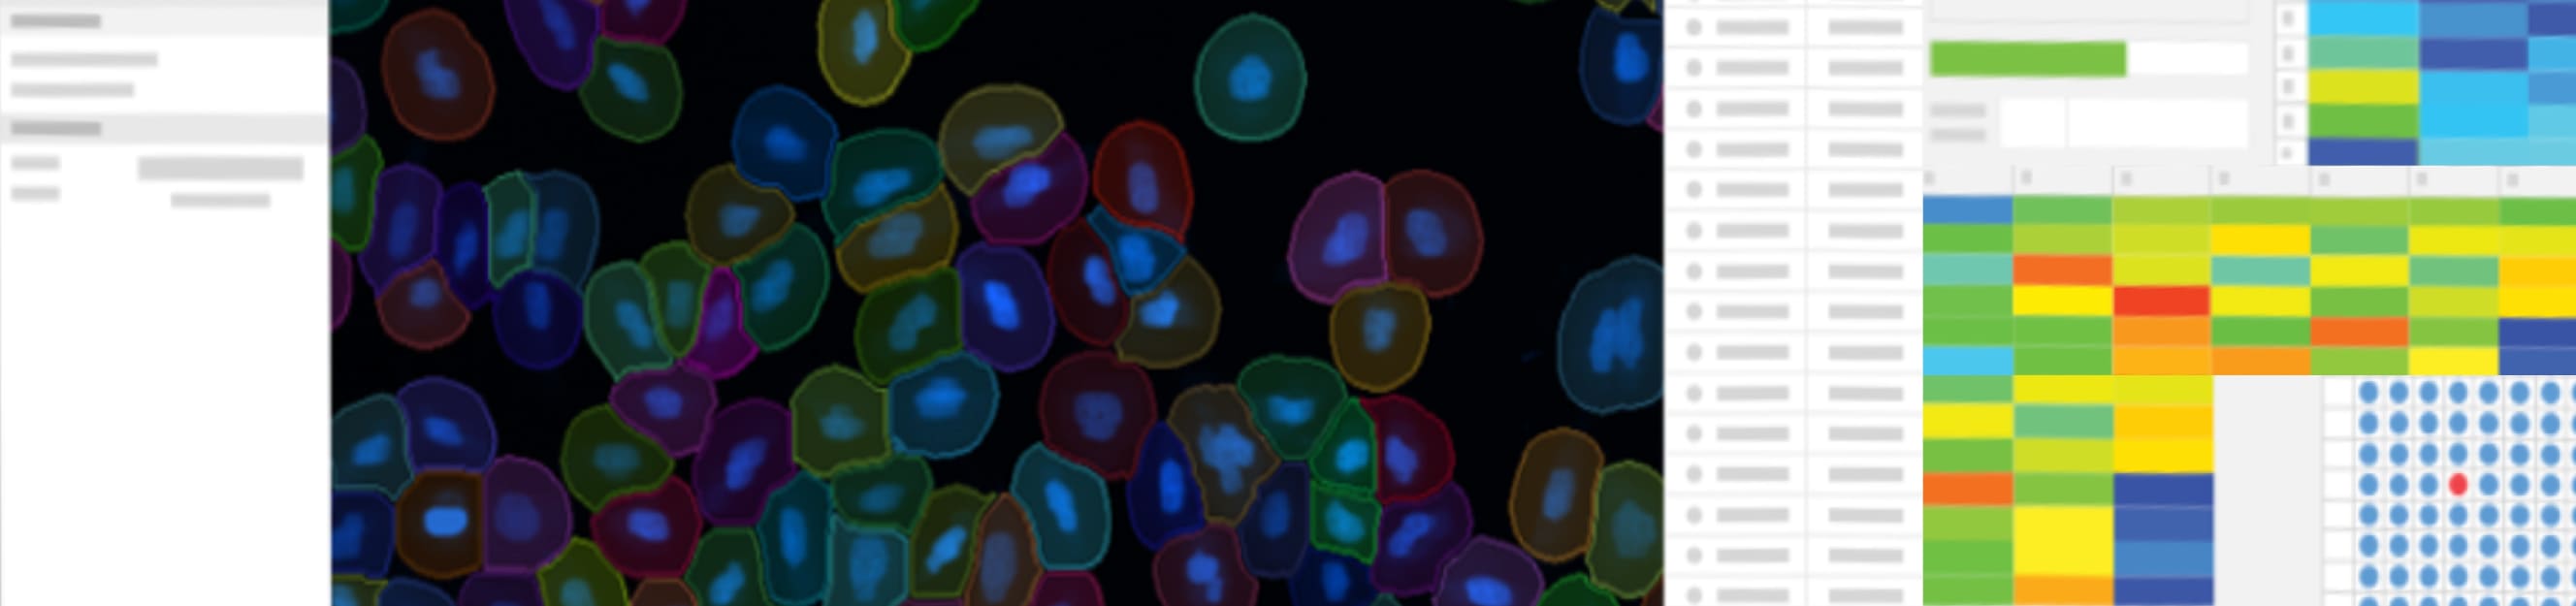
-

Practical image analysis using AI/Machine Learning and Image-Pro software
In this practical, application-focused webinar, we demonstrate how AI-based image analysis can be used to extract reliable, quantitative data from SEM images from start to finish using Image-Pro software connected to Hitachi SEMs
Building on a previous webinar that introduced the principles of machine learning and AI for image segmentation, this session shifts the focus to real-world use cases. We will walk through complete analysis workflows, starting with SEM image acquisition and ending with validated numerical results such as size distributions, area fractions, layer thickness, and defect statistics.
Through selected examples, we show how AI-assisted segmentation can be trained, refined, and applied in ImagePro, and how the resulting measurements can be reviewed, exported, and used for reporting, R&D, and quality control. The emphasis is on transparency, reproducibility, and practical implementation rather than theory.
This webinar is aimed at users who want to move from “AI curiosity” to confident, everyday use of AI-driven image analysis in electron microscopy.
What you will learn:
- How to set up an end-to-end AI image analysis workflow in Image-Pro
- Practical training and validation of AI-based segmentation models
- How to extract quantitative results from SEM images (size, shape, area, thickness, defects)
- Best practices for ensuring robust, repeatable, and explainable results
- How Image-Pro integrates with Hitachi SEMs for efficient analysis workflows
- How to export and use data for reporting, R&D, and QC applications
Speakers

Mats Eriksson
CEO, Spectral AB


